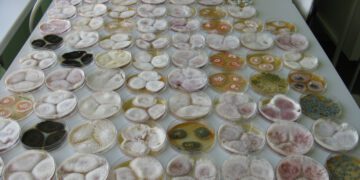
Saastumise riski määramine METK Saku laboris.

Augusti lõpus andsid Eesti Rukki Selts ja MTÜ Külvaja üle rukkikülvaja auhinna. Tänavu tõsteti esile Raido Allsaart koos isa Hendrik Allsaarega, kelle Järvamaal asuvad põllud on juba aastaid andnud head rukkisaaki.
Raido Allsaar on õppinud Estonian Business Schoolis (EBS) rahvusvahelist ärijuhtimist. Kui ta aastal 2011 maale elama tuli, oli talupidamiseks vaja juurde õppida praktilisemaid oskusi ja liisk langes Olustvere teenindus- ja maamajanduskooli taimekasvatuse erialale. „Eks need teadmised kõik koos töötavad – nii isalt saadud oskused, taimekasvatuse erialane taust kui ka äriteadmised EBS-ist,“ möönab Allsaar. „Olen võtnud põllumajandust kui tavalist tootmist. Selles vallas on küll ilmastikuriskid, kuid kõik, mida sai ülikoolis õpitud tootmis- ja finantsjuhtimisest, kehib ka siin ja on me pereettevõttele aluse pannud. Ka on isa kogu aeg nõu ja jõuga abiks olnud: tarkused ei tule ühe ropsuga ja nii koguneb neid aina juurde.“
Kuid kas talupidamine on äri või elustiil? Raido Allsaare vastus on kiire: mõlemad kokku. Ta kannab edasi kodutalu traditsiooni, kus tootmine on igapäevaeluga üks tervik. Et aga töö saaks hästi tehtud, tuleb kõike teha maksimumiga: „Oma kodutalu annab väga suure emotsiooni ja tõuke. Linnas elades ei oleks nii hingega asja juures ja tegemist oleks lihtsalt äriga.“
Sajandijagu peretalu
Saabume koos fotograafiga Imavere lähistel Taadikvere külas asuvasse Essa-Reinu tallu korraliku sügisilmaga – meid ei hellita tuul ega vihm ning mantlihõlmad tuleb korralikult koomale tõmmata. Maja ümber ootavad talvekorda seadmist traktorid ja põllutöömasinad, põllul on tärganud talioder.
Talukoht on pere valduses olnud üle sajandi. Mägede OÜ on 2003. aastal isa Hendrik Allsaare kodutalust välja kasvanud pereettevõte, mis on keskendunud teraviljakasvatusele, talvel tehakse metsatöid. Kokku on põllumaad 1400 hektarit, metsamaa pindala jääb paari-saja hektari lähedale.
Kui möödunud aegadel oli vanas laudas 27 lehma, siis täna piiluvad meid vaid mõnede lihaveiste uudishimulikud pead. Raido Allsaare sõnul on lihaveiste pidamine praegu pigem hobi. Samas saab rohumaadelt niidetavat heina loomasöödana kasutada ja lõpuks heinasööjatest ka maitsvat vorsti.

Nüüdseks on Raido Allsaar kodutalus toimetanud kümme aastat. „Alguses oli kohusetunne, siis tuli motivatsioon ja ka kerge hasart. Kogu aeg saab ju paremini,“ võtab mees kümnendi kokku ja möönab, et selle aja jooksul on talu pindalalt kolm korda suuremaks kasvanud. Kasvanud on ka tööjõuvajadus: palgal on kuus inimest.
Soojal ajal töö, talvel puhkus
Hooajal venivad tööpäevad pikale: kell kuus on äratus ja õhtul kümnest saab magama. Allsaar on aga kindel, et ka puhkust peab endale lubama: „Kui enne jaani saavad olulised tööd tehtud, võtame juuli keskpaigani rahulikumalt. Samuti puhkame kogu jõulukuu.“
Töö ja vaev on ennast ära tasunud. Aastal 2019 kirjutasid Allsaared enda nimele seni kehtiva viljelusvõistluse saagirekordi: 12,1 tonni hektarilt. „Eks teraviljasort oli hea, aga ka aasta oli hea. Kui ilmastik tulemusele kaasa aitab, on see ainult boonus. Oma tööd teed ikka ju nii hästi, kui saad,“ jääb Allsaar tagasihoidlikuks. Tänavuse aasta septembri alguses anti Raido ja Hendrik Allsaarele üle ka 2021. aasta rukkikülvaja auhind.
Kõige raskemate hetkedena mäletabki Allsaar koristusaegseid vihmaseid päevi: „Vaatad akna peal ja ei saagi midagi teha.
Meele teeb heaks see, kui töömeestel on näod naerul, töö jookseb ilusti ja tuleb ka tulemus.
Üksinda ei tee ju midagi, kõik on meeskonnatöö,“ on Allsaar kindel. Usalduslikus ja pingevabas õhkkonnas sünnivadki suured asjad. „Kui meeskonna sees tekivad pinged, tuleb need lahendada ja vajadusel teha raskeid valikuid.“
Kuhu, kuidas ja kas?
Raido Allsaar toob välja kolm suurt küsimust, millele iga teraviljakasvataja peaks vastuse leidma: mida kuhu külvata, kuidas harida ja kas jõuad kõik ära teha.
Kodust, EBS-ist ja Olustverest omandatud teadmiste abil saab teha poole rehkendusest. Allsaar nendib, et finantspoole ja üldise juhtimisega saab hakkama koolist saadud teadmiste baasil. „Väga oluline on ära tabada hetk, kui kulud hakkavad tulusid sööma ehk teisisõnu – liiga suurt ampsu pole mõtet ette võtta ja tuleb aru saada, mis tööd on olemasolevate inimestega optimaalne ära teha. Olen jälginud, et meie ettevõtmine ei läheks liiga suureks, eesmärk on saada hektarilt võimalikult suur saak.”

Lisaks tehnikale uuenevad igal aastal taimekaitsevahendid, väetised ja teraviljasordid. „Peabki vaatama, kuidas oma maade eest nii hoolitseda, et mullaproovid oleksid korras, ära tabama hetke, kui väetised on odavamad, et neid siis osta. Oleme pidevalt investeerinud ka maasse, välja vahetanud masinapargi, korrastanud laod ja kuivatid. Nüüd algab juba teine ring,“ rõhutab Allsaar, et tasemel tehnika aitab poole tööst ära teha ja toodangut kasvatada.
Nõu ei häbeneta küsida
Pikki aastaid on toeks olnud Peeter Viil Eesti Taimekasvatuse Instituudist, Annika Jõemaa ja Tiia Lige Baltic Agrost ning Janne Ehte-Tammiste Bayerist. „Aeg-ajalt käime koos põllul. Nad vaatavad, kas oskavad midagi soovitada,“ selgitab Raido Allsaar.
Ühe tähtsa tegevusena toobki Allsaar välja sordivaliku ja selle pideva uuendamise: „Seemneid tuleb sorteerida, korralik seeme välja valida, puhtida ja analüüsida. Samuti tuleb kogu aeg järge hoida, et sertifitseeritud seeme saaks uuendatud. Kui ühel aastal mingit kultuuri ei uuenda, siis järgmisel aastal teen seda kindlasti.“
Mägede OÜ-s kasvatatakse talinisu ja -otra, suviotra, rukist ja hernest. Põllumaadel on kultuurid pidevas ringluses – seal, kus kasvas mullu talirukis, on järgmisel aastal maas mingi muu kultuur. Harimisviiside asjus on Allsaare sõnul teadmistega abiks olnud Peeter Viil. „Tema oskab täpselt soovitada, millised harimisviisid mulda rikastavad ja millised mitte. Vastavalt sellele oleme harimisagregaate ostnud,“ sedastab Allsaar.
Murelikuks teeb Allsaart aga Euroopa Liidu uue programmperioodi rahastusmudel, kus toetused võivad väheneda ligi poole võrra. „Rohestamine on kahtlemata vajalik, kuid nõudeid välja töötades ei ole ametnikud küsinud nõu praktikutelt. Näiteks allakülvi tegemine on väga iganenud mõtteviis mullastiku parandamiseks, selle harimiseks ja hooldamiseks kulub väga palju kütust. On olemas palju efektiivsemaid praktikaid ja just selliseid, mis ei jäta maad tootmisest välja.“
Kõhutunne ja teadmised
Kuhu toodang panna, kas fikseerida hind, müüa börsil? Raido Allsaare sõnul tuleb neid otsuseid langetada kõhutunde ja kogemuse põhjal. „Algusaastatel olin traktori peal, vedasin vilja ja tegin jooksvaid töid. Nägin, et kui ühel päeval ei jõudnud börsi jälgida ja hind polnud fikseeritud, võisin päevaga kaotada 10 000–20 000 eurot. Et tekiks õige vaist, peab börsil toimetades jälgima aasta hindasid, lugema erialast infot ja leidma piisavalt aega teemaga tegelemiseks.“
Allsaar toob näite: „Kui Eestis väideti, et hinnad lähevad alla, siis tegelikult toimus 13. augustil hoopis meeletu hinnatõus. Kui mu hind oleks olnud fikseeritud, oleksin 50 eurot tonni pealt vähem saanud ehk kaotanud üle 300 000 euro.“
Samas pole Allsaare sõnul vaja alati ka tippu püüda: „Pigem peaks vaatama, et keskmine tuleks välja ja mõtlema, kuidas oma riske hajutada – midagi fikseerid ära, midagi jätad fikseerimata.“
Veel üks kümnend
Kümne aasta pärast tahab Raido Allsaar sellesama Essa-Reinu talu õues seista. „Talu tuleb edasi arendada. Kui tehnikainvesteeringud tehtud, on vaja neli-viis hoonet korda teha, metsad tahaks korda saada, ja ajaga tuleb nagunii kogu aeg kaasa joosta,“ loetleb ta.
Allsaar möönab, et Mägede OÜ kõrvale võiks mahtuda veel mõni ettevõte, mida hobi korras majandada. Pealehakkamist on mehel juba varasest nooruspõlvest saati. Nimelt kogunes aastal 2003 Riigikogu istungisaali Laste
Parlament ja Jaanus Männiku kohal istus toona Raido Allsaar. Ühiskonnaelus aktiivne olemine ei ole Allsaarest tänaseni mööda läinud. „Otseselt poliitikas ma ei osale, kuid nii kohalikul kui ka riigi tasandil on inimesi, kellega saan asju arutada ja nõuga aidata.“
Enne mõtleb, siis teeb
Peeter Viil, Eesti Taimekasvatuse Instituudi vanemteadur
Raido Allsaar on noor ja innovaatilise mõtlemisega põllumees, kes enne kaalub, kui midagi teeb. Kõige olulisem on see, et ta on keskkonnasõbralik tootja.
Kui intensiivselt haritavatel põldudel on orgaanilise aine mineralisatsioon kiirem kui akumulatsioon, siis Allsaarte perel on see vastupidi: mõeldakse tuleviku peale, et muld tehnoloogiate kasutamisel rikastuks. Allsaar harib põlde pindmiselt ja hoiab sellega mullaelustikku. Samuti tagastab ta mulda taimede põhu, mis soodustab orgaanilise aine akumulatsiooni. Uue suunana külvatakse lämmastikku siduvaid vahekultuure, mis parandab mulla tervist ja vähendab sügisel toitainete väljaleostumist.